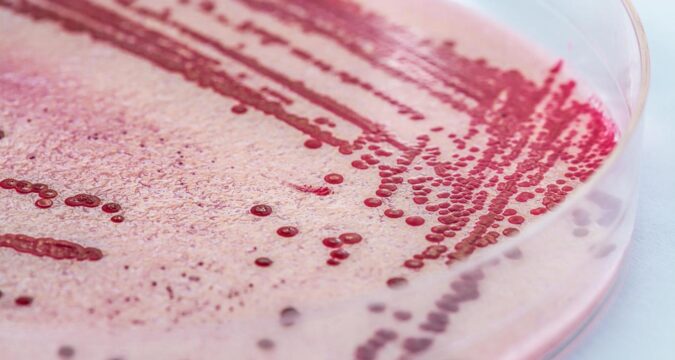

By David J. Neal, Miami Herald
Two more products have been recalled in relation to the listeria outbreak, with four deaths traced to prepared pasta meals, one recall that involves Publix, Walmart and likely other chains as well as independent stores.
The other recall involves Kroger and Kroger-owned chains.
Those recalls were the major change in Friday’s FDA update on the outbreak, credited with sickening 20 people and killing four, one of which was a fetus, over 15 states.
READ MORE: Listeria outbreak and pasta dishes sold under Walmart, Kroger, Trader Joe’s brands
Scott & Jon’s shrimp and pasta recall
Nate’s Fine Foods of Roseville, California, a suburb of Sacramento, pulled five lots of Scott & Jon’s Shrimp Scampi with Linguini: S254522, best by 3/12/2027; S255522, best by 3/13/2027; S259522, best by 3/17/2027; S263521 and S263522, best by 3/21/2027.
While several supermarket chains and independent stores sell Scott & Jon’s pasta and seafood dishes, as of Sunday morning, Publix and Walmart were the major chains that announced on their websites they were hit by this recall.
Walmart listed stores in the District of Columbia, Puerto Rico and these 42 states as being involved: Florida, California, North Carolina, South Carolina, Missouri, Texas, Kentucky, Georgia, Mississippi, Pennsylvania, Illinois, Alabama, Arkansas, Arizona, Colorado, Connecticut, Delaware, Iowa, Idaho, Indiana, Kansas, Louisiana, Maryland, Michigan, Minnesota, Montana, North Dakota, South Dakota, Nebraska, New Jersey, New York, Nevada, Ohio, Oklahoma, Oregon, Tennessee, Utah, Virginia, Vermont, Wisconsin, West Virginia and Wyoming.
Return the boxes of shrimp scampi to the store for a full refund or throw it deep in the garbage. If you have any questions, call Demers Food Group, 800-239-9731, Monday through Friday, 8 a.m. to 4 p.m. Eastern time.
Kroger pasta recalls
Kroger recalled Basil Pesto Bowtie Salads and Smoked Mozzarella Penne Salads sold from Aug. 29 through Thursday at Kroger and owned chains Ralphs, Dillons, Fred Meyer, Baker’s, City Market, Fry’s, King Soopers, Gerbes, Payless, and Smith’s.
This covers stores in California, Washington, South Carolina, Missouri, Texas, Kentucky, Alaska, Alabama, Arkansas, Arizona, Colorado, Georgia, Idaho, Illinois, Indiana, Kansas, Louisiana, Michigan, Mississippi, Montana, Nebraska, New Mexico, Nevada, Ohio, Oregon, Tennessee, Utah and West Virginia.
If the salads are in your freezer or refrigerator, throw them out or return them to the store for a full refund. If you have questions, call Kroger at 800-KROGERS, Monday through Friday, 8 a.m. to midnight, Eastern time, Saturday and Sunday, 8 a.m. to 9 p.m.
_____
©2025 Miami Herald. Visit miamiherald.com. Distributed by Tribune Content Agency, LLC.

